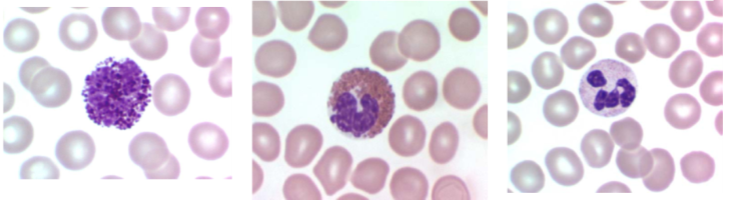
term image

innate and adaptive immunity
1/17
There's no tags or description
Looks like no tags are added yet.
Name | Mastery | Learn | Test | Matching | Spaced | Call with Kai |
|---|
No analytics yet
Send a link to your students to track their progress
18 Terms
innate immunity - mechanical defence
body surface = skin, fur
cilia in respiratory tract
air movement in respiratory tract
flushing by fluids e.g tears, urine, diarrhoea
mucus as barrier
immunity
CMP = common myeloid progenitor
CLP = common lymphoid progenitor
innate immunity
first line of defence with multiple forms - mechanical, molcular/cellular, microbiological and enviromental
natural or non-specific
speed
memory
specifity
innate immunity - physiological defence
pH changes and extremes
pyrexia kills some infectious agents
cellular innate defences
monocyte - only in blood stream, then becomes a macrophagein tissue
macrophages - function by ingesting and killing microorganisms
neutrophils - phagocyctic and degranulate
mast cells/ basophils/ eosinophils

basophil
eosinophil
neutrophil
molecular defences
defensins
lysozyme and sweat gland secretions
myeloperoxidase system
acute phase proteins
complement system
interferons
defensins
small proteins(15-20 amino acids)
found in many tissues and cells(esp phagocytes and epithelial cells)
active against bacteria, fungi and viruses(bind microbe membrane)
important in skin barrier to infections
lysozymes
family of enzymes which attack peptidoglycan cell walls of bacteria
sites of action =
cellular - cytoplasmic granules of macrophages
secreted from epithelial cells - tears, saliva, mucus
sebum - from sebaceous glands, waxy - fatty acids - stop bacterial attachment to skin, hydrates and lubricates skin
myeloperoxidase
enzyme found mainly in lysosomes in granulocytes and macrophages
kills bacteria and other pathogens by production of toxic hypochlorite(OCl-) and single oxygen(O2)

innate immunity - microbiological defence commensal bacteria
inhabit mucosal surfaces, esp in GI, respiratory tracts and skin
innate immune system is always primed and functioning against commensal bacteria but it has a tolerance which prevents inflammation
prevent attachment of pathogenic bacteria and block invasion and infection

enviromental/ management effects on innate immunity
husbandry - diet, temp and humidity
form of immunodeficiency
adaptive immunity
built from 2 cells - T and B cells(lymphocytes)
defining features = specificity, self/ non-self discrimination, memory
all adaptive immune cells go through maturation in thymus, to make sure that all of B and T cells you have in your body do not recognise any part of self
B and T cells in body will recognise any antigen presented to them
antigen
any molecule that can bind specifically to an antibody or antigen recpetor
epitope
site on an antigen recognised by an antibody or an antigen receptor
antibody
protein that binds specifically to particular substance
recognises a specific epitope
primary and secondary immune responses
vaccine contains antigen which has specific epitope
innate immune system then present it to adaptive immune system
one of T-cells or B-cells will recognise it and undergo clonal expansion to multiply - takes time and dies down
t or b cell goes through selective process to make bind better
once dies off still exists as memory cell in blood
primed and ready to expand
so if reinfection occurs the second response is faster and larger
so adaptive immune system is most useful in re-infections

stages of action - defending against microbial invasion
